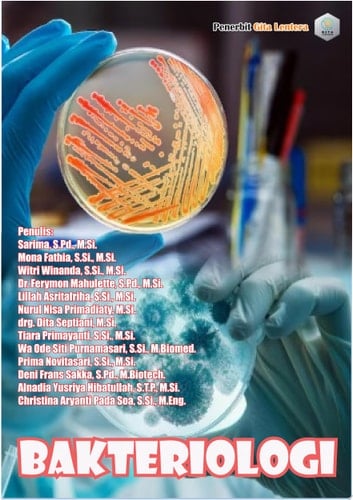
Bakteriologi

Bakteriologi
0
0
Author Description
Buku Bakteriologi ini merupakan panduan ilmiah yang menyeluruh mengenai dunia bakteri, organisme mikroskopis yang memiliki pengaruh besar terhadap kehidupan di bumi. Disusun berdasarkan referensi ilmiah terkini dan penelitian modern, buku ini membahas secara mendalam struktur, fisiologi, metabolisme, genetika, serta peran bakteri dalam berbagai bidang mulai dari kesehatan, lingkungan, pertanian, hingga industri bioteknologi. Diawali dengan pengantar tentang definisi, sejarah, dan ruang lingkup bakteriologi, pembaca akan diajak menelusuri perjalanan ilmiah dari penemuan mikroorganisme oleh Antonie van Leeuwenhoek hingga revolusi bioteknologi masa kini. Bab-bab berikutnya menjelaskan karakteristik morfologi dan fisiologi bakteri, mekanisme metabolisme dan adaptasi terhadap lingkungan, serta implikasi bakteri dalam kehidupan manusia dan ekosistem global. Selain membahas konsep klasik seperti Postulat Koch dan teori biogenesis, buku ini juga memaparkan isu-isu kontemporer seperti resistensi antibiotik, peran mikrobioma dalam kesehatan, dan pemanfaatan kecerdasan buatan dalam identifikasi mikroba. Di akhir, pembaca diajak memahami tren terbaru seperti metagenomik, CRISPR, dan bioteknologi sintetis yang menjadi tonggak baru dalam riset bakteriologi modern.
Page Count:
225
Publication Date:
2025-11-06
ISBN-10:
634742228X
ISBN-13:
9786347422286